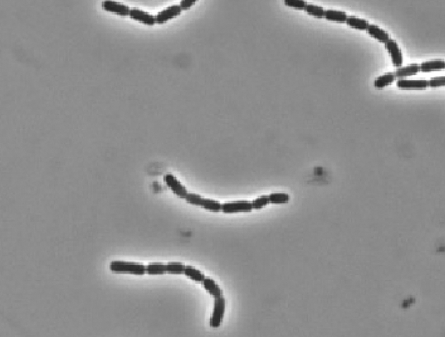

변비를 예방하기 위해서 아이들이 먹는 유산균 종류가 정말 많은데요.
저도 그전부터 아이 변비 때문에 푸룬 주스, 다른 유산균들도 많이 먹여봤습니다.
나름 효과가 있었지만, 문제는 아이들이 꾸준히 먹기 위해서는 아이들마다 제 각각인 까다로운 입맛에 맞아야겠죠.
아이들이 좋아할 만한 맛을 가진 유산균을 알아보다가 구매한 것이 롯데헬스원 말랑이 생유산균입니다.

롯데헬스원 말랑이 생유산균 1박스입니다.
1박스는 60g으로, 2g 30포가 들어있습니다.
우선 포장부터 말랑카우와 쏙 닮은 젖소가 그려져 있어서 아이들의 거부감이 없을 것 같네요.
롯데헬스원 말랑이 생유산균은 포도맛과 요거트맛 2종류가 있는데, 저는 포도맛을 선택했습니다.

롯데헬스원 말랑이 생유산균 박스 뒷면에는 제품 정보가 상세히 표기되어 있습니다.
원재료를 살펴보면, 유산균 혼합 분말, 산화아연, 건조효모, 프락토올리고당, 결정 분말 포도당, 자일리톨, 포도과즙 분말, 식물성 크림 분말 등 상당히 많은 재료들이 들어 있네요.
프로바이오틱스 유산균과 유산균 먹이인 프리바이오틱스가 함께 함유된 신바이오틱스라고 합니다.
유산균 외에도 비타민C, D 등의 성분도 함유되어 있습니다.

롯데헬스원 말랑이 생유산균의 영양정보를 살펴보면, 1포(2g) 당 10kcal로, 탄수화물 2g, 프로바이오틱스 수 100,000,000 CFU, 아연 2.55mg, 비타민D 10ug가 함유되어 있습니다.

롯데헬스원 말랑이 생유산균 박스 측면에는 섭취량, 방법 등이 표기되어 있습니다.
1일 1회, 1회 1포를 섭취하라고 하네요.

롯데헬스원 말랑이 생유산균 박스를 개봉해보면, 2g 1포씩 개별 포장되어 있습니다.
총 30포가 가득 차 있는 모습이네요.


롯데헬스원 말랑이 생유산균 1포 포장에도 귀여운 말랑카우와 같은 젖소 그림이 있습니다.
이지컷 형태로 포장되어 손쉽게 뜯을 수 있네요.
내용물은 흰색의 가루인데요.
입자가 고와서 먹기에 부담스럽지 않습니다.
1포를 먹어보니, 맛은 달달한 포도맛이 나는데, 아주 많이 달지는 않습니다.
친숙한 포장 때문인지 달달한 포도맛 때문인지 다행히도 아이들이 거부감 없이 잘 먹는 모습인데요.
꾸준히 먹여서 그 효과를 지켜봐야 할 것 같습니다.
아이들이 유산균 먹기를 꺼려하신다면, 아이들에게 친숙한 포장과 맛의 롯데헬스원 말랑이 생유산균을 추천합니다.

'리뷰' 카테고리의 다른 글
| 노브랜드 추천상품 우엉차 후기 (0) | 2022.11.03 |
|---|---|
| 종합비타민 추천 라이프 익스텐션 투퍼데이 멀티비타민 (0) | 2022.11.03 |
| 시리얼 추천 포스트 팝콘 그래놀라 바삭 오리지널 (0) | 2022.10.25 |
| 순후추 라면 후기 (0) | 2022.10.21 |
| 통영 맛집 짬뽕시간 후기 (0) | 2022.10.10 |